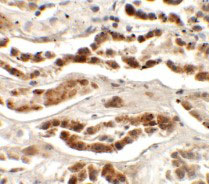
IHC - LZTS2 Antibody ASC11420

LZTS2 Antibody
- SPECIFICATION
- CITATIONS
- PROTOCOLS
- BACKGROUND

Application
| WB, IHC-P, IF, E |
|---|---|
| Primary Accession | Q9BRK4 |
| Other Accession | NP_115805, 45331215 |
| Reactivity | Human, Mouse |
| Host | Rabbit |
| Clonality | Polyclonal |
| Isotype | IgG |
| Calculated MW | 72759 Da |
| Application Notes | LZTS2 antibody can be used for detection of EPAC1 by Western blot at 1 µg/mL. Antibody can also be used for immunohistochemistry starting at 2.5 µg/mL. For immunofluorescence start at 20 µg/mL. |
| Gene ID | 84445 |
|---|---|
| Target/Specificity | LZTS2; LZTS2 antibody is predicted to not cross-react with other LZTS family members |
| Reconstitution & Storage | LZTS2 antibody can be stored at 4℃ for three months and -20℃, stable for up to one year. As with all antibodies care should be taken to avoid repeated freeze thaw cycles. Antibodies should not be exposed to prolonged high temperatures. |
| Precautions | LZTS2 Antibody is for research use only and not for use in diagnostic or therapeutic procedures. |
| Name | LZTS2 {ECO:0000255|HAMAP-Rule:MF_03026} |
|---|---|
| Function | Negative regulator of katanin-mediated microtubule severing and release from the centrosome. Required for central spindle formation and the completion of cytokinesis. May negatively regulate axonal outgrowth by preventing the formation of microtubule bundles that are necessary for transport within the elongating axon. Negative regulator of the Wnt signaling pathway. Represses beta-catenin-mediated transcriptional activation by promoting the nuclear exclusion of beta- catenin. |
| Cellular Location | Cytoplasm. Cytoplasm, cytoskeleton, microtubule organizing center, centrosome. Note=Localized to the centrosome throughout the cell cycle. Localized to the midbody in cells undergoing cytokinesis |
| Tissue Location | Highly expressed in prostate and testis, and at slightly lower levels in spleen, thymus, uterus, small intestine and colon. |

Thousands of laboratories across the world have published research that depended on the performance of antibodies from Abcepta to advance their research. Check out links to articles that cite our products in major peer-reviewed journals, organized by research category.
info@abcepta.com, and receive a free "I Love Antibodies" mug.
Provided below are standard protocols that you may find useful for product applications.
Background
LZTS2 Antibody: The leucine zipper putative tumor suppressor 2 (LZTS2, also known as LAPSER1), a member of the LZTS family, is a negative regulator of the Wnt signaling pathway. It represses beta-catenin-mediated transcriptional activation by promoting the nuclear exclusion of beta-catenin. LZTS2 is involved in cytokinesis and regulates katanin-mediated microtubule severing and release from the centrosome. LZTS2 may negatively regulate axonal outgrowth by preventing the formation of microtubule bundles that are necessary for transport within the elongating axon. LZTS2 is highly expressed in testis and prostate, but it is deleted in multiple cancers, including prostate tumors, suggesting that LZTS2 acts as a potential tumor suppressor.
References
Thyssen G, Li TH, Lehmann L, et al. LZTS2 is a novel beta-catenin-interacting protein and regulates the nuclear export of beta-catenin. Mol. Cell. Biol. 2006; 26:8857-67
Sudo H and Maru Y. LAPSER1/LZTS2: a pluripotent tumor suppressor linked to the inhibition of katanin-mediated microtubule severing. Hum. Mol. Genet. 2008; 17:2524-40.
Sudo H and Maru Y. LAPSER1 is a putative cytokinetic tumor suppressor that shows the same centrosome and midbody subcellular localization pattern as p80 Katanin. FASEB J. 2007; 21:2086-100.
Cabeza-Arvelaiz Y, Thompson TC, Sepulveda JL, et al. LAPSER1: a novel candidate tumor suppressor gene from 10q24.3. Oncogene 2001; 20:6707-17.
If you have used an Abcepta product and would like to share how it has performed, please click on the "Submit Review" button and provide the requested information. Our staff will examine and post your review and contact you if needed.
If you have any additional inquiries please email technical services at tech@abcepta.com.













 Foundational characteristics of cancer include proliferation, angiogenesis, migration, evasion of apoptosis, and cellular immortality. Find key markers for these cellular processes and antibodies to detect them.
Foundational characteristics of cancer include proliferation, angiogenesis, migration, evasion of apoptosis, and cellular immortality. Find key markers for these cellular processes and antibodies to detect them. The SUMOplot™ Analysis Program predicts and scores sumoylation sites in your protein. SUMOylation is a post-translational modification involved in various cellular processes, such as nuclear-cytosolic transport, transcriptional regulation, apoptosis, protein stability, response to stress, and progression through the cell cycle.
The SUMOplot™ Analysis Program predicts and scores sumoylation sites in your protein. SUMOylation is a post-translational modification involved in various cellular processes, such as nuclear-cytosolic transport, transcriptional regulation, apoptosis, protein stability, response to stress, and progression through the cell cycle. The Autophagy Receptor Motif Plotter predicts and scores autophagy receptor binding sites in your protein. Identifying proteins connected to this pathway is critical to understanding the role of autophagy in physiological as well as pathological processes such as development, differentiation, neurodegenerative diseases, stress, infection, and cancer.
The Autophagy Receptor Motif Plotter predicts and scores autophagy receptor binding sites in your protein. Identifying proteins connected to this pathway is critical to understanding the role of autophagy in physiological as well as pathological processes such as development, differentiation, neurodegenerative diseases, stress, infection, and cancer.